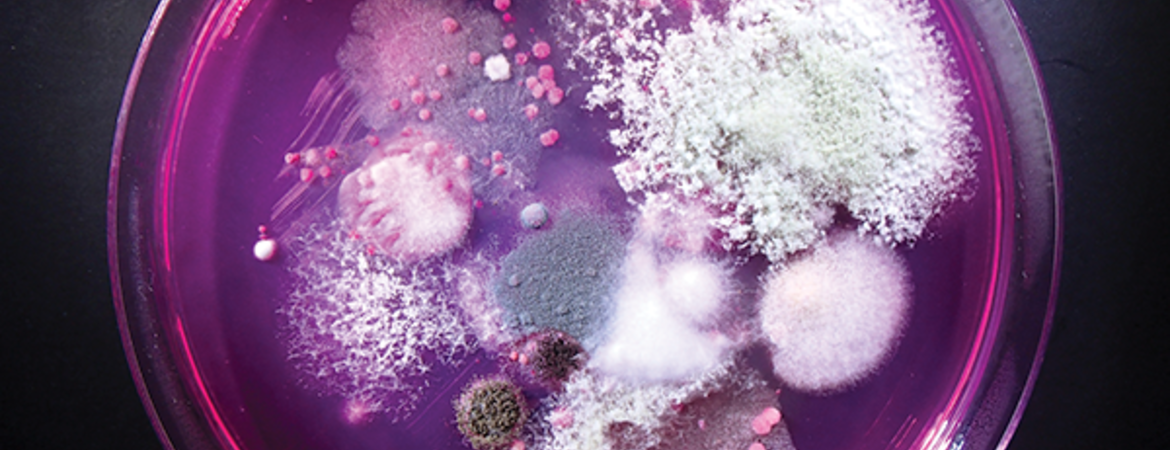

Jason Stajich and Hailing Jin joined a class of 73 total fellows elected to the American Academy of Microbiology. The academy is a leadership group of scientists from around the globe within the American Society of Microbiology elected annually through a selective, peer-reviewed process.
Additionally, Stajich was elected as a fellow of the Mycological Society of America this summer, a distinction awarded for a record of solid research, successful teaching, and significant service to society. He also joined the 2020 class of fellows of the American Association for the Advancement of Science (AAAS) for his research into the evolution of fungi and other microorganisms.
This Inside UCR article was written by Jules Bernstein and can be viewed here.